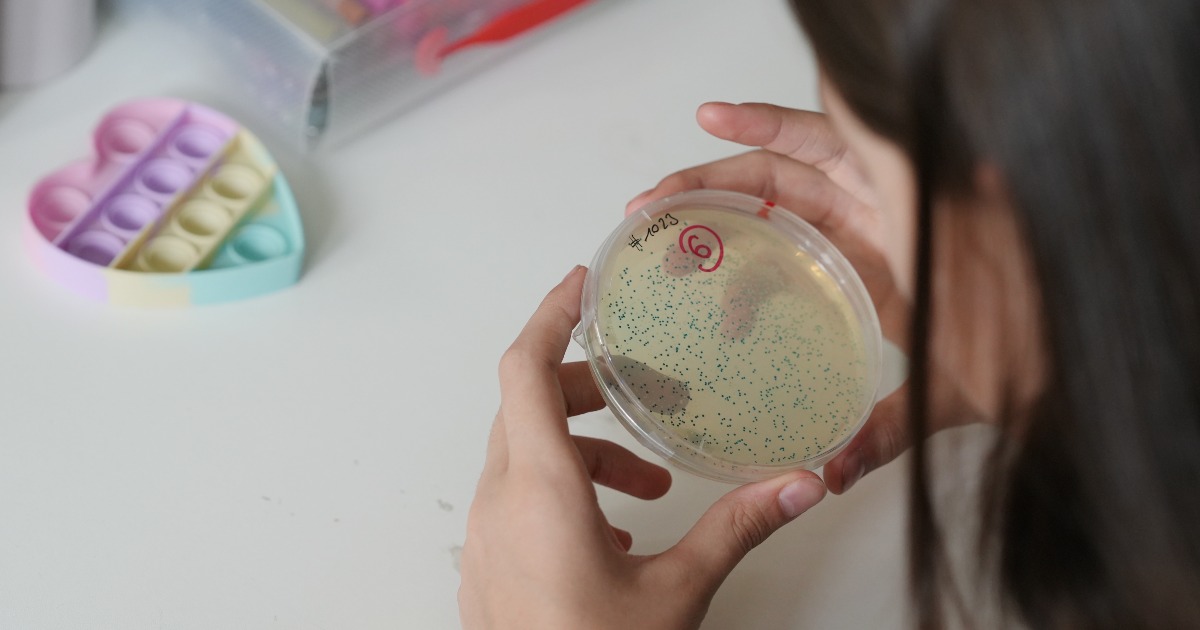
Image
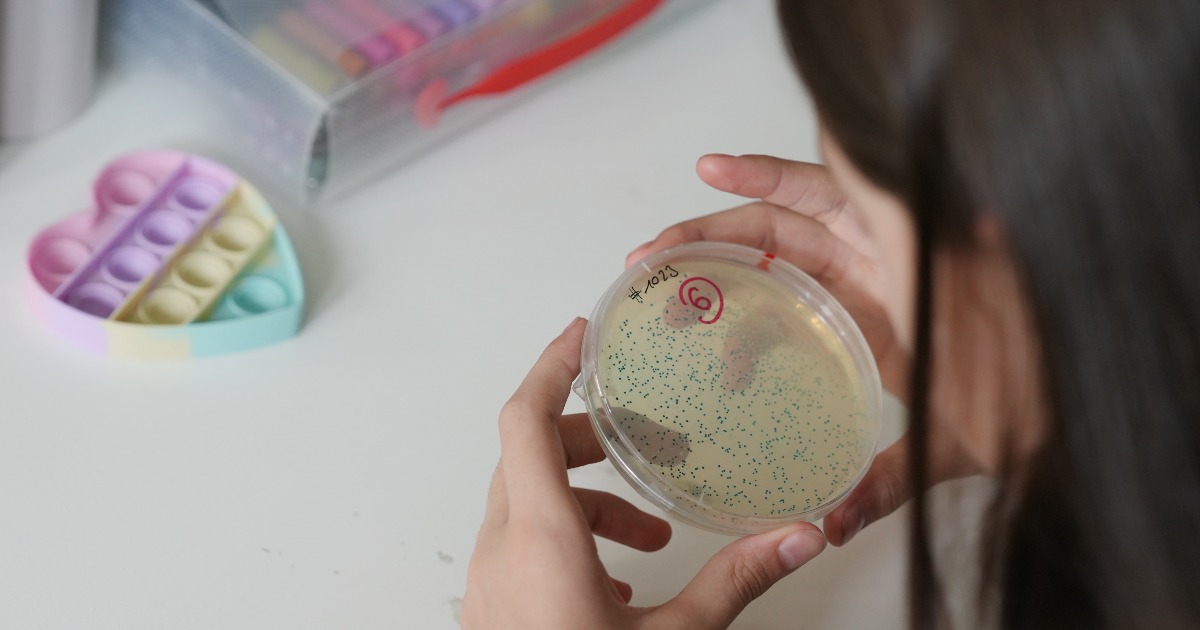
Image

Associazione Mercurio
Mission
Associazione Mercurio è un’associazione culturale e di promozione sociale attiva a Milano e in Lombardia dal 2014.
L’associazione affianca la scuola pubblica, con l’obiettivo di contribuire a contrastare la dispersione e l’abbandono scolastico, offrendo pari opportunità di crescita e di inclusione a bambini e ragazzi provenienti da categorie fragili e contesti socio-economici svantaggiati.
Negli anni, l’associazione ha coinvolto nei suoi progetti didattici ed educativi oltre 150 scuole pubbliche e più di 30.000 studenti.
Le nostre attività
Proponiamo percorsi didattici innovativi rivolti a bambini e ragazzi provenienti da contesti con forte fragilità sociale e povertà educativa.
Le nostre proposte educative gratuite per le scuole promuovono l’inclusione, la partecipazione attiva e il benessere psico-emotivo di bambini e ragazzi tramite l'interazione, l'emozione, la creatività e l'ascolto.
Attraverso l'arte, la creatività, la scienza e tecnologia e lo sport, i nostri progetti mirano a valorizzare la multidisciplinarietà, le competenze e l'ascolto di sé' supportando i più giovani nel loro percorso di crescita personale e collettiva.
Grazie al coinvolgimento di attori e contesti significativi nell’ambito della formazione, del mondo professionale, della creatività e dell’innovazione, offriamo nuove prospettive di pensiero a bambini e ragazzi.
Mercurio valorizza le capacità e le attitudini individuali per incentivare il senso di autostima e la realizzazione personale. L’associazione sviluppa iniziative educative mirate al sostegno, alla formazione e all’inclusione dei giovani, con l’obiettivo di creare valore sociale e stimolare una crescita emotiva positiva nei ragazzi.
Per conoscere e sostenere Mercurio: http://www.associazione-mercurio.org/
Raccolta fondi e benefici fiscali
Puoi scegliere di correre per noi alla Milano Marathon unendo la tua sfida sportiva a quella solidale creando la tua pagina di raccolta fondi personale (personal fundraising) collegata alla nostra campagna attiva su Rete del Dono oppure semplicemente puoi donare, sempre sulla nostra campagna, in totale sicurezza e trasparenza scegliendo tra bonifico bancario, carta di credito, PayPal o Satispay. Dopo aver effettuato la donazione è possibile scaricare la ricevuta per accedere ai benefici fiscali previsti dalla legge, quali le detrazioni o le deduzioni fiscali. Qui maggiori approfondimenti: https://www.retedeldono.it/landing/retedeldonofisco